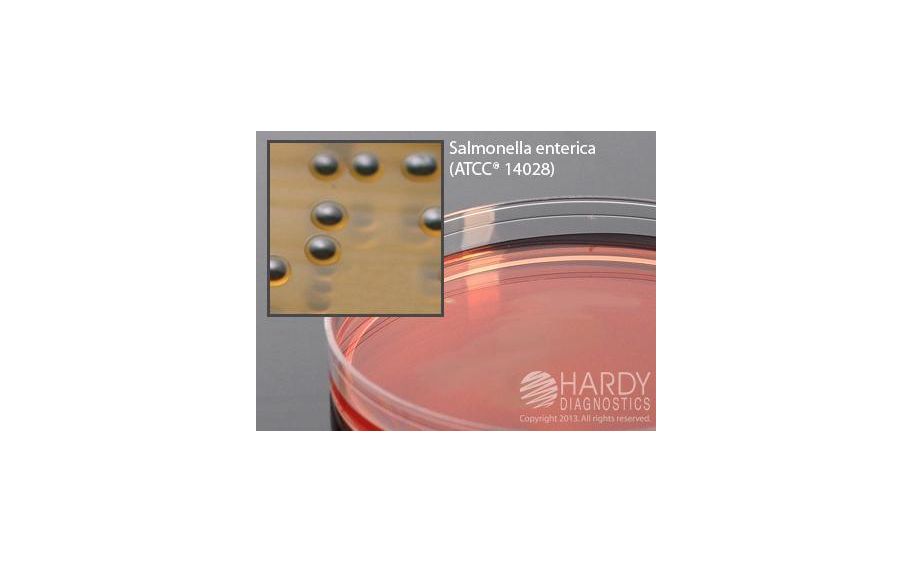
main product photo

Need Help?
800-229-7252

MEDIUM SS AGAR 15X100MM PLATED PK10
1
/
PK
Lead Time
12 Day(s)
SKU
VWR89413-496-PK
MFRPN
G50
MEDIUM SS AGAR 15X100MM PLATED PK10
Ss (Salmonella Shigella) Agar, 15X100Mm Plate Order By The Package Of 10. For The Isolation Of Pathogenic Enteric Bacteria, Especially Salmonella Spp., By Hardy Diagnostics.
| Manufacturer | Hardy Diagnostics |
|---|---|
| MFRPN | G50 |
| Lead Time | 12 Day(s) |
| UNSPSC Code | 12000000 |
Write Your Own Review